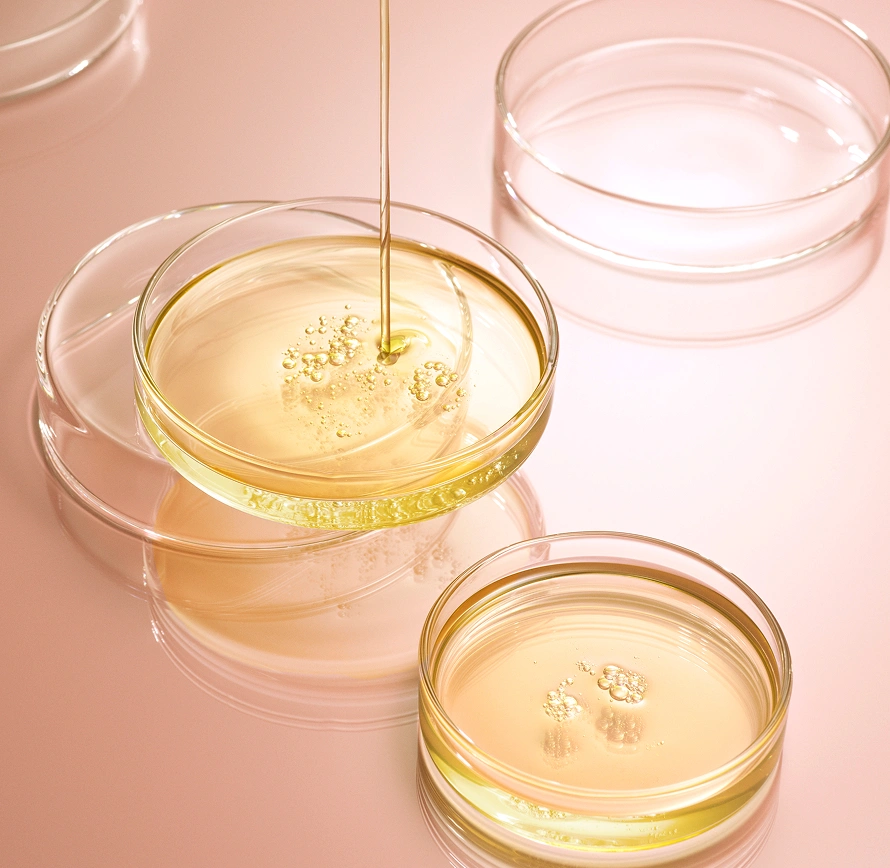

- HOME HOME
- CONCEPT CONCEPT
- METHOD METHOD
-
PRODUCTS
-
ONLINE STORE

※MOISTシリーズ:全洗浄成分のうち、PPT系洗浄成分を約35%配合。

「毛髪構成成分※2」を中心に、37種類の
補修成分で設計された9つの独自処方が、
複合的に毛髪にアプローチする
新たなヘアケアシステムです。
モイストでは、NO.01~07の
処方を採用しています。
REVITAL CHARGE
毛髪の主成分である高配合のケラチンPPTが洗いながら毛髪内部に浸透し集中補修
タンパク質加水分解物(PPT)洗浄成分※1
BASE PRIMER
傷んだ毛髪のコンディションを整えカラーケア効果と共になめらかな質感に導く
pH調整剤※3、カチオン性高分子※4
NANO REFACTOR
微細化した複数の疑似CMC成分が毛髪内部まで潤いを与え柔軟性のある髪へ
ナノCMCセラミド※5
ELASTIC SHOT
様々なアミノ酸の複合体が髪の内側まで浸透し毛髪に弾力としなやかさを付与
超低分子コラーゲン※6、アミノコンプレックス※7
Re:PROTECTION
キューティクル脂質成分と複数のケラチンが毛髪外部を保護し、指通りを向上
18-MEA※8、高分子ケラチンPPT※9、中分子カシミヤケラチンPPT※10
Phyto-FILM
髪馴染みが良く自然なツヤを引き出す厳選された植物オイルが毛髪表面をコーティング
植物油※11
CORE HYDRATION
ヒアルロン酸やコラーゲンなどの高保湿成分が髪の芯まで集中的に潤いを補給
カチオン化ヒアルロン酸※12、超低分子コラーゲン※6、ラクトン誘導体※13、その他保湿成分※14

SLEEK TOUCH
複数のケラチンと様々な質感補整成分がダメージ部位にアプローチし、なめらかな指通りへ導く
高分子ケラチンPPT、カチオン化ケラチンPPT、その他テクスチャー補整成分

ADSORB LAYER
被膜形成ケラチンやラクトン誘導体が毛髪表面に吸着しドライヤーやアイロンによる熱ダメージもケア
シリル化シルクPPT、シリル化ケラチンPPT、ラクトン誘導体

自然な指通りのまま、毛髪の広がりを抑制※15。
贅沢配合した19種類の毛髪構成成分※2由来の補修成分が、毛髪内部のコルテックスを補修。不自然なベタつきや重さを感じない自然な指通りを実現。素髪のままで扱いやすい髪へと導きます。

日々使い続けることで、髪の質感向上※16。
最適なバランスで配合したケラチンやシルク由来の洗浄成分※1が、さまざまな髪質に作用。洗うたび毛髪のダメージ部分を補修し、髪のベースから整えていきます。


爽やかなレモン、ベルガモット、グレープフルーツをトップに、ローズやピオニー、ミュゲ、ジャスミンが優しく包み込み、さらにアンバーとバニラ、サンダルウッドが加わった、凛とした気品とぬくもりが共存する柔らかな香り。まるで時間という概念から解き放たれるように、心地よく静かに広がる華やかさを演出します。

PPT系洗浄成分※1など、あらゆる補修成分を高配合した独自処方では、長期の品質維持が難しいため、買い替え用はボトルタイプを採用。中身を注ぎ替えるのではなく、毎回新しいボトルをお届けし、ポンプを付け替えてご使用いただくことを推奨しています。